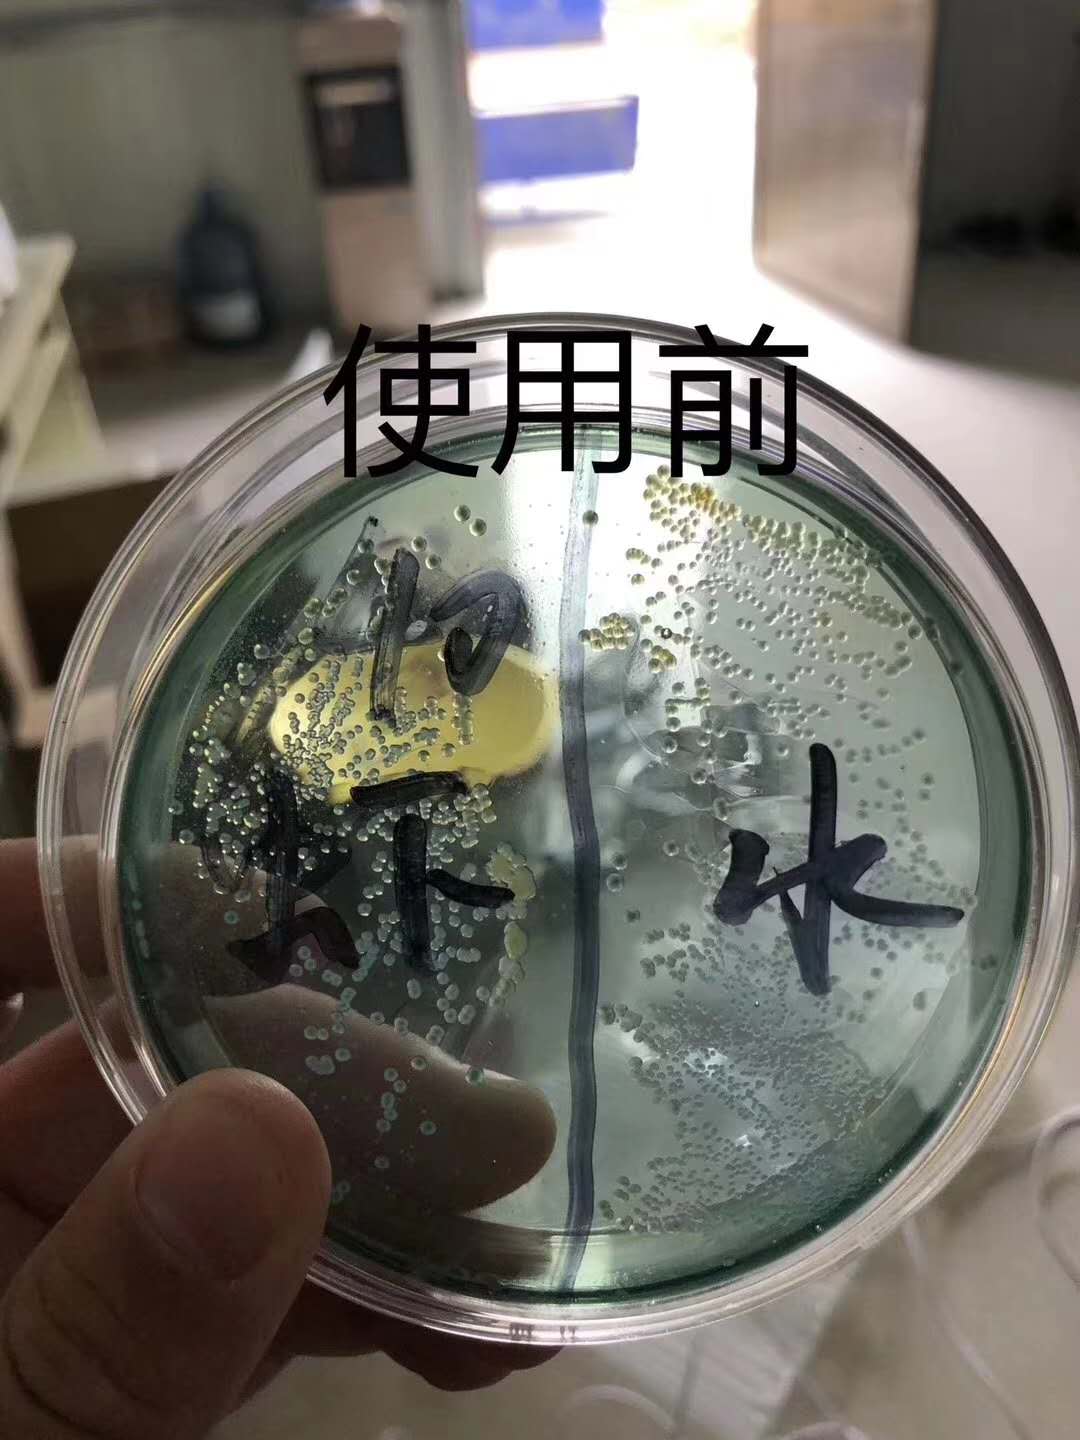
好水养好鱼鱼池,水产养殖水质过硬怎么办

老化的水体,俗称“老水”,大多呈暗绿色或铜绿色,水色浓,水体悬浮物较多,浑浊,透明度低,低于20公分。
(此处已添加圈子卡片,请到*今条头日**客户端查看)
池塘底部长时间不清理淤泥,池塘底部的残饵及粪便未及时清理,在高温季节,池塘水体就特别容易老化。水中浮游植物数量多,但藻类单一,细胞老化,老化或衰败的藻体常于池塘下风口聚积形成绿色泡沫。

老化水体,抵御环境影响造成的水质波动能力差,水质不稳定,易发生“倒藻”、“泛塘”、有害水质指标升高等不良现象,是不利养殖生物生长。

一、引起水体老化的原因
1.溶氧不足
水体溶氧不足,一方面养殖品种正常的生命活动受到抑制,影响正常生长、繁殖;另一方面水中物质进行厌氧循环,产生许多有毒物质,直接毒害水产品。
2.有机物积累过多
有机物积累过多,厌氧分解占优,底质和底层水积累大量有毒物质。
3.氮、磷比例不当
适当的氮磷比是5~12:1,低于或高于这个范围都是不适当的氮磷比。少的一方成为限制因子,多的一方不能被利用而积累转变成有害物,限制水体生产力。
4.代谢废物特别是氨积累太多
水生生物的代谢产物特别是氨如果积累太多,会对水生动物和养殖品种产生毒害作用,降低水体生产能力,甚至引起养殖品种的死亡。
5.pH值过高或过低
水体pH值过高或过低,都会引起一些营养物质的沉淀、吸附,使水体正常的物质循环速度降低甚至停止,水体生产力低下;

另一方面pH值过高或过低,水生生物正常的生理活动也受到抑制,生长速度缓慢甚至停止,引起水质变化,鱼虾应激。
二、水体老化的危害
1、水色转浓,严重发黑发红,甚至倒藻泛塘。
藻类大量繁殖,聚集形成水华,池塘下风口水浓绿,早上或阴雨天水色往往偏红黑色,俗称“酱油水”,极易引起缺氧泛塘。

2、养殖动物缺氧浮头,吃食变差、活动能力变差。
水体老化,养殖动物吃食变差,严重的不吃料。池塘溶氧大部分是来源于水体中浮游植物光合作用产氧,水质老化后藻类产氧能力下降,夜间养殖动物、浮游生物、底泥中的微生物等都会呼吸消耗大量氧气,致使养殖动物出现缺氧吃食不好,甚至引起浮头、上草上岸,时间一长,养殖动物体质下降、活动能力变差。
3、水体自净能力变差、亚硝酸盐超标。
藻类老化后,吸收利用氨氮和亚硝酸盐的能力也减弱,这也是为什么有部分池塘水很肥,亚硝酸盐偏高的原因,一般水肥的池塘亚硝酸盐不会偏高。

三、水体老化的处理方法
1、清淤改底。
塘底淤泥含有大量有机物和病菌。塘底淤泥有机物难以分解,随着残饵粪便的日积月累,塘底污染加剧,成为有害病菌滋生的温床。应该清淤、消毒改底,去除氨氮、亚硝酸盐、硫化氢等有害物质,达到改善水质的目的。
2、增氧机增氧。
老化水体较容易缺氧,应注意及时开启增氧机增加水体溶氧,以促进水体物质循环、转化分解池底有害物质。增氧机按照“三开两不开”原则合理使用,同时使用缓释型增氧片。

3、池塘换水。
补充新水或更换水体是解决池水老化的好方法。换的水体应为水质良好、溶氧丰富、无污染。每次更换的水量不宜超过池塘水量的1/3,以免水质波动较大造成养殖生物出现应激反应。
4、补充有益菌调水。
水源条件不好、加水困难的池塘,在养殖过程中应定期施用底质改良剂或微生态制剂,EM菌、光合细菌、枯草芽孢杆菌等,增加池底溶氧,促进衰亡藻体分解,降解有害物质,改善水环境;补充有益菌群分解有机质,抑制藻类生长,能有效改善养殖动物吃食。
